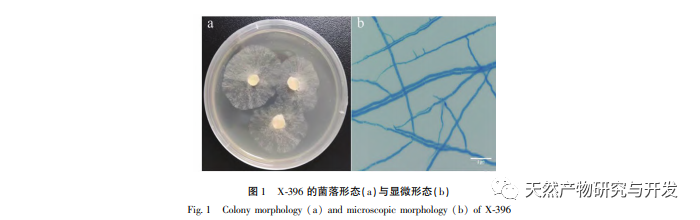

Isolering og identifikation af den endofytiske svamp X-396 fra fennikel og analyse af lipidopløselige komponenter i dens fermenterede produkt
Planteendofytiske svampe refererer til svampe, der ofte er til stede i sundt plantevæv, men som generelt ikke forårsager plantesygdomme. De udvikler sig sammen med værtsplanter for at danne stabile økologiske forhold og kan producere bioaktive stoffer, der er de samme eller forskellige fra værtsplantens. Forskning har vist, at næsten alle undersøgte planter indeholder endofytiske svampe, også lægeplanter. Endofytiske svampe i lægeplanter er en ekstremt rigelig og ny mikrobiel ressource med et stort antal og en bred fordeling. Der er mange typer værtsplanter, og deres forhold til dem er ekstremt komplekst. De kan producere forskellige aktive produkter og har brede udsigter til udvikling og anvendelse. I forbindelse med langsom naturlig regenerering af lægeplanter, lav udvinding af aktive ingredienser og reduceret biodiversitet forårsaget af overdreven menneskelig indgriben er dybdegående forskning i endofytiske svampe og deres metabolitter i lægeplanter en af de effektive måder at beskytte sjældne lægeplanter på og opnå storstilet produktion af medicinske ingredienser. I de senere år har forskere isoleret mange strukturelt nye og meget aktive monomere forbindelser fra endofytiske svampes sekundære metabolitter. Naturprodukter fremstillet gennem svampemetabolisme har betydelige fordele i forhold til udbytte, økonomi og miljøbeskyttelse sammenlignet med lægeplanter.
Tibetanske lægeplanter indeholder på grund af deres vækst i højtliggende områder med store temperaturforskelle, lav nedbør, lang lyseksponering og stærk stråling unikke aktive ingredienser og biologiske aktiviteter, hvilket gør dem til en vigtig kilde til naturmedicin eller blyforbindelser. Den tibetanske medicin Hypecoum leptocarpum Hook. f. et Thoms. er en tørret hel plante af slægten Hypecoum i familien Papaveraceae. Den tibetanske medicin kaldes "Balbada", som har en bitter smag og en kold natur. Den har en varmeafledende, afgiftende, antiinflammatorisk og smertestillende virkning. Det bruges hovedsageligt til at behandle influenza, lungebetændelse, hoste, ledsmerter, ondt i halsen, lindre madforgiftning og er velegnet til forskellige infektionssygdomme, der forårsager feber. På nuværende tidspunkt fokuserer forskningen i denne lægeplante hovedsageligt på planteressourcer, kemisk sammensætning og biologisk aktivitet, og der er kun lidt opmærksomhed på dens endofytiske svampe. Derfor har udvinding af aktive forbindelser fra den stor forskningsværdi og videnskabelig betydning. Denne undersøgelse isolerede og rensede en endofytisk svamp X-396 fra fennikel og identificerede den. De lipidopløselige komponenter i dens fermenteringsprodukt blev analyseret ved hjælp af GC-MS-teknologi, og dens antitumoraktivitet blev undersøgt ved hjælp af CCK-8-metoden. Det forventes at give et vist datagrundlag og en referenceværdi for effektiv udnyttelse af endofytiske svamperessourcer i fennikel og udvikling af nye antitumoraktive blyforbindelser i fremtiden.

Denne undersøgelse analyserede de lipidopløselige komponenter i det fermenterede produkt af den endofytiske svamp X-396 i fennikel ved hjælp af GC-MS. For at øge flygtigheden af dets lipofile komponenter og adskillelsen af lignende komponenter udførte denne undersøgelse derivatiseringsbehandling før GC-MS-analyse. Resultaterne af GC-MS-analysen viste, at sammenlignet med de 17 lipidopløselige komponenter, der blev identificeret i værtsplanten fennikel, var de bioaktive komponenter i de lipidopløselige komponenter i det fermenterede produkt af den endofytiske svamp X-396 mere forskelligartede og indeholdt en stor mængde sterolforbindelser. På grund af den lignende struktur af plantesteroler er det vanskeligt at identificere deres typer nøjagtigt. I denne undersøgelse blev tre standardprøver af brassinosteroider, stigmasterol og β-sitosterol udvalgt til derivatisering og GC-MS-detektion, og steroltyperne i de lipidopløselige komponenter i X-396-fermenteringsproduktet blev i sidste ende bestemt. Det relative indhold af ergosterol og β-sitosterol var henholdsvis 31,83% og 12,00%. Ergosterol er en vigtig komponent i svampecellemembraner. På grund af dets stabile struktur og stærke specificitet kan dets indhold bruges som en indikator for svampebiomasse og fremme optagelsen af calcium og fosfor i menneskekroppen. Det er en af de gode kilder til eksogent vitamin D2 til menneskekroppen. β-sitosterol er et sikkert, naturligt, grønt og effektivt kosttilskud til mennesker, der ikke giver genetisk eller cellulær toksicitet. Kliniske forsøg og undersøgelser af modeldyr har bekræftet, at β-sitosterol har forskellige biologiske aktiviteter såsom kolesterolsænkende, blodsukkersænkende, antioxidante, antiinflammatoriske, antibakterielle og kræfthæmmende egenskaber.
Gennem GC-MS-analyse blev aktive ingredienser som methylhexadecanoat, laktræssyre og squalen identificeret fra X-396-fermenteringsproduktet. Blandt dem er methylhexadecanoat en mide-dræbende forbindelse, der kan hæmme fagocytisk aktivitet og immunrespons. Der er også litteraturrapporter om, at det har antiinflammatoriske virkninger. Lacktræssyre har antiinflammatoriske og antiangiogene virkninger. Squalen, som er et forstadie til steroidsyntese, deltager i stofskiftet og spiller en vigtig rolle i syntesevejene for β-caroten, coenzym Q10, D-vitamin, E-vitamin og K1-vitamin. Derfor kan squalen spille en vigtig rolle i anti-inflammatorisk, antioxidant, hud- og kardiovaskulær beskyttelse.
Med hensyn til in vitro-aktivitetsscreening har de lipidopløselige komponenter fra X-396-fermentering bedre antitumoraktivitet mod HepG-celler. Denne undersøgelse beriger forskningen i sammensætningen af endofytiske svampefermenteringsprodukter fra fennikel og giver visse datareferencer og et videnskabeligt grundlag for den efterfølgende aktivitetsforskning af endofytiske svampefermenteringsprodukter fra fennikel.
